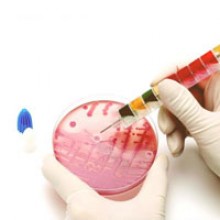

- 0487 - 2321347
- Mon-Sat 10:00 AM to 5:00 PM
- info@chemik.in
- Chemicals for Inorganic Analysis
- Organic Synthesis
- Pharmaceutical
- Microscopy
- Electrochemistry
- Titration
- Centrifugation
- Liquid Handling
- Weighing
- Incubators
Rapid tests including PCR and real-time PCR tests, molecular biology reagents, consumables and equipment.

Since 1996 chemik chemicals are one of the best laboratory supplier satisfying the needs of a variety of customers like hospitals, speciality labs, research labs, scientific institutions and industria
Read More
Chemik products are distinguished by innovative design, durability, reliability, and value. you can benefit even more form our excellent stand-alone products by using them together as a system; in so
Read More
We essentially stand in for them in this market place, providing same level of support they would themselves.These synergistic Partnership allows us to give you access to abroad selectionof products
Read More